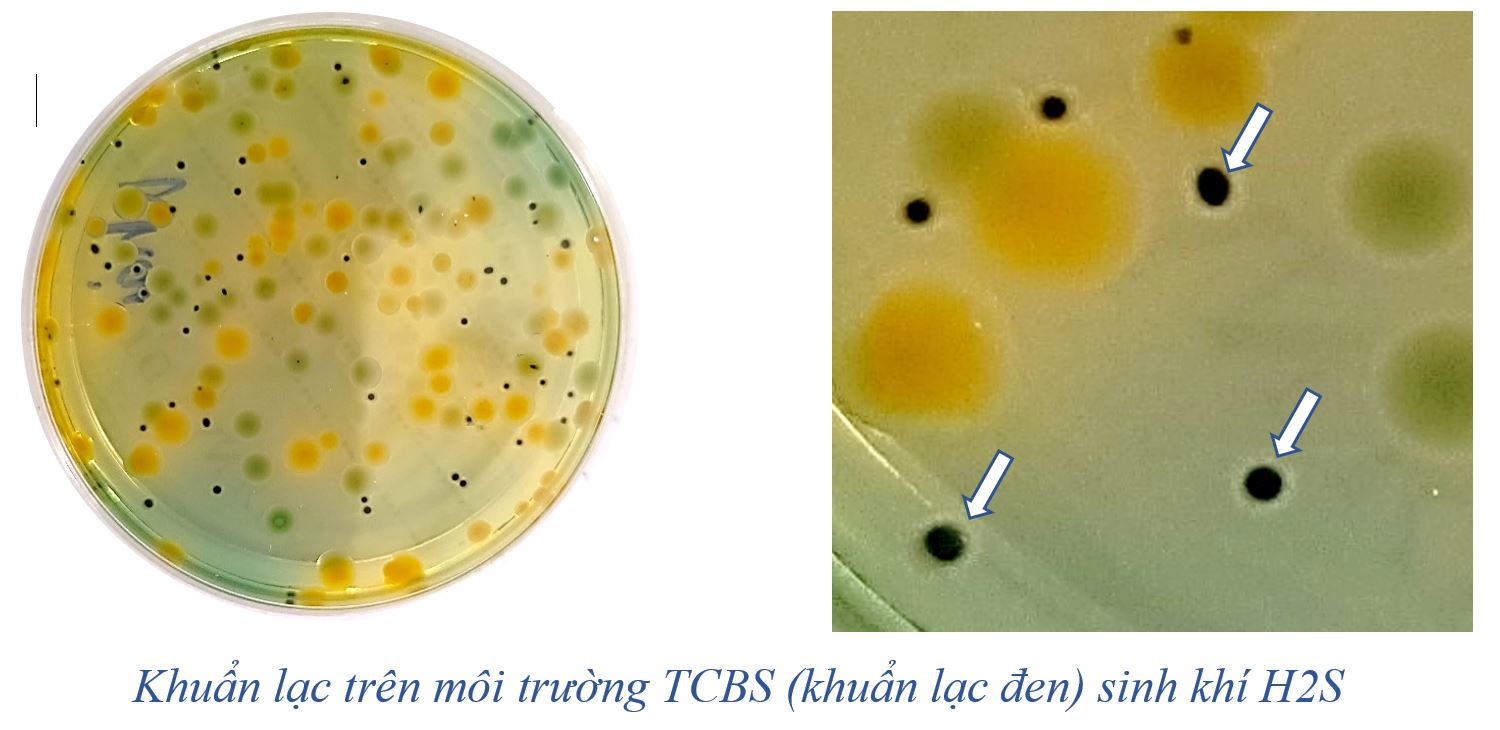

HOW TO MANAGE TOXIC GASES IN SHRIMP PONDS SAFELY - SAVINGLY - EFFICIENTLY AND SUSTAINABLY
Currently, the trend of raising high-tech models at high density has caused shrimp farming to encounter many obstacles due to diseases and pollution of water sources in ponds and farming areas. There are three main types of toxic gases in ponds: NH3, NO2, and H2S, which are often toxic and affect farmed shrimp.
Image: Manage toxic gases in shrimp ponds efficiently and sustainably
1. What is the cause of toxic gas formation in shrimp ponds?
Toxic gases in shrimp ponds are caused by:
- Excess feed, according to research by Boyd et al. (2001) the feed used directly by shrimp only accounts for 10-30% of phosphorus and 20-40% of nitrogen from the feed, the rest will dissolve in the water environment and participate in the physical metabolism process in the body. Water bodies, under anaerobic conditions, are decomposed by bacteria into substances that are toxic to the pond and surrounding water sources
- Algae remains and accumulated shrimp waste decompose at the bottom of shrimp ponds in conditions of lack of oxygen. in which nitrogen-containing compounds such as NH4+, NO2- in high concentrations can be toxic to shrimp.
When shrimp is poisoned, it often has the following symptoms:
- Shrimp body is light red.
- Shrimp shells become soft.
- Swimming lazily on the surface of the water.
- Reduce eating.
- In case heavy situation, shrimp can pull up on the shore and die scattered or mass.
Image: Shrimp is red body by toxic gas
II. Common toxic gases in shrimp ponds
1. Signs of Ammonia gas (NH3):
In water, ammonia is divided into 2 groups: NH3 group (dissolved gas) and NH4+ group (ionized), only the NH3 form of ammonia is Toxic to shrimp, NH3 is 300 to 400 times more toxic than NH4+. The main cause is shrimp waste and the decomposition of organic matter under the action of bacteria.
According to Siripong and Rittmann (2007). Ammonia content at 0.425mg/L in water environment can be toxic to shrimp and other aquatic animals. NH3 is often harmful to shrimp in the afternoon, when pH increases (if you increase 1 pH unit, the ratio of NH3 will increase 10 times) and when water color changes. Ponds with strongly developed bottom algae will have high NH3 gas content. What are the harmful effects of NH3 toxic gas on shrimp?
- Ammonia is directly toxic to the shrimp's respiratory system, causing physiological imbalance, reducing resistance and leading to shrimp death
- Reduces oxygen in the pond, requiring 4.7g of oxygen to oxidize 1g of NH3.
Image: Signs of NH3 in ponds
2. Signs of NO2 toxic gas
The cause of existence originates from NH4+/NH3 Under the action of bacteria, ammonia will change into nitrite (NO2) (by Nitrosomonas bacteria) than nitrate (NO3-) (by Nitrobacter bacteria) or it is also possible that NO2 already exists in the supply water. The nitrate form is usually harmless, nitrite is toxic to shrimp. According to Advocate Global Aquaculture, 2013, the allowable NO2 content is < 0.25mg/L. If it exceeds 0.3mg/L, it will inhibit oxygen transport in the blood, causing great toxicity to livestock. What are the harmful effects of NO2 toxic gas on shrimp? Nitrite is toxic mainly by forming methemoglobin and reducing oxygen transfer to cells. Stress, and disease susceptibility, cause death.
Image: Signs of NO2 in ponds
3. Signs of Hydrogen sulfide gas (H2S)
This gas is very toxic to shrimp. In the water environment, hydrogen sulfide is divided into 2 groups: H2S group (gas) and HSˉ(ion). Cause of formation: bacteria operating in low conditions. lack of oxygen. Only the H2S form (gas) is toxic. Its toxic effect is to bind with Fe in the hemoglobin component or Cu in hemocyanin, causing cells to lose the ability to transport oxygen, leading to slow and rapid growth of shrimp. Low survival rate due to lack of oxygen.
According to Chanratchakkol et al. (2003), the appropriate H2S content for shrimp ponds must be less than 0.03 mg/L. In addition, the toxicity of H2S also depends on many factors such as pH and water temperature.
For example: in ponds with pH = 5 and at 24℃, people see 99.1% of hydrogen sulfide in the form of H2S, while at pH = 8 with the same temperature of 24℃, only 8% of hydrogen sulfide is in the form of H2S. poison. Signs of H2S in the pond.
- Ponds with black mud often have a lot of H2S gas.
- Dark black colonies appear on TCBS.
Image: Colonies on TCBS medium (black colonies) produce Hydrogen sulfide gas (H2S)
III. Managing toxic gases in shrimp ponds
To avoid toxic gas outbreaks in shrimp ponds, we need to strictly manage the following issues:
- Manage the amount of feed from the beginning to avoid excess feed.
- Raise shrimp at an appropriate density, stocking density should not be too thick.
- It is necessary to have a pond to change water regularly to reduce water environmental pressure.
- At the same time, increase the running of the water fan system. When operating the water fan, it creates a strong radial flow, ensuring that the water in the pond is evenly stirred, while removing solid waste such as dead shrimp carcasses and leftover feed, shrimp feces, shrimp by-products, etc. easily accumulate in the middle of the pond bottom, convenient for collecting and treating siphons according to technical procedures. Thanks to that, the bottom is kept clean throughout the farming season, minimizing harmful bacteria and toxic gases accumulating in the pond environment.
- Periodically check microbial streams to treat waste and prevent outbreaks of toxic gases
- Build an automatic siphon system to regularly siphon the pond bottom, to minimize waste in the environment, it is best to siphon after turning off the fan for shrimp for 20-25 minutes.
Image: preparing fan system in shrimp pond
IV. How to handle toxic gases in shrimp ponds
1. Mechanical measures
- Regularly siphon to remove waste from the pond
- Perform strong water changes every day to dilute the concentration of toxic gases in the pond
- Increase oxygen to a high level in the pond
2. Biological measures
- Use microbial strain O3 (227g/1000 m3) alternating with NITRO 18 (227g/1000 m3) in the pond's periodic microbiological cycle, supplementing beneficial bacteria to decompose organic matter and waste. shrimp helps stabilize algae and pH, and creates tea color for water, thereby controlling increased toxic gases and stabilizing the water environment.
There are 2 ways to use microorganisms:
• O3 microorganisms and NITRO 18 (directly into the pond),
• Anaerobic incubation with a dosage of 1 package of O3 microorganisms (227g) + 5kg of molasses + 180L of water, incubated for 24 hours and discharged into the pond at 8:00 a.m.
- Combine with ALKALITE to increase alkalinity, increase pH, stabilize the buffer system for ponds, supplement calcium for shrimp
- You should use ENJOY powder to help prevent feed from spoiling. Loose, crushed, shrimp feces are tougher and firmer, thereby limiting the particles in the water and making the pond water cleaner. Dosage: 5-7g/kg of feed, can be mixed directly or mixed into water and then mixed into feed.
Contact us now: at WhatsApp: +84939881532 (Mrs. Camryn Ho) or leave a comment below to receive more advice about managing toxic gas levels in shrimp ponds and O3, NITRO 18 Probiotics from us. We wish farmers had successful shrimp and fish seasons and high prices!
.......................................................................................
MY BINH EXPORT-IMPORT TRADING LIMITED COMPANY
Main Office: 49/11B, Tran Hoang Na Street, Hung Loi Ward, Ninh Kieu District, Can Tho City, Viet Nam.
Factory Address: 28T, Nguyen Van Quy Street, Phu Thu Ward, Cai Rang District, Can Tho City, Viet Nam.
Hotline: +84911383533 or +84983173322
Website: https://mybinh.com.vn
Email: mbtrade9@gmail.com